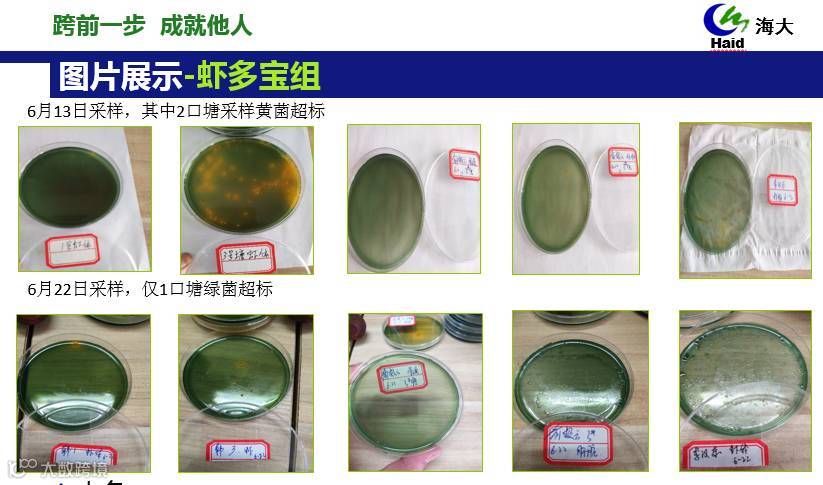
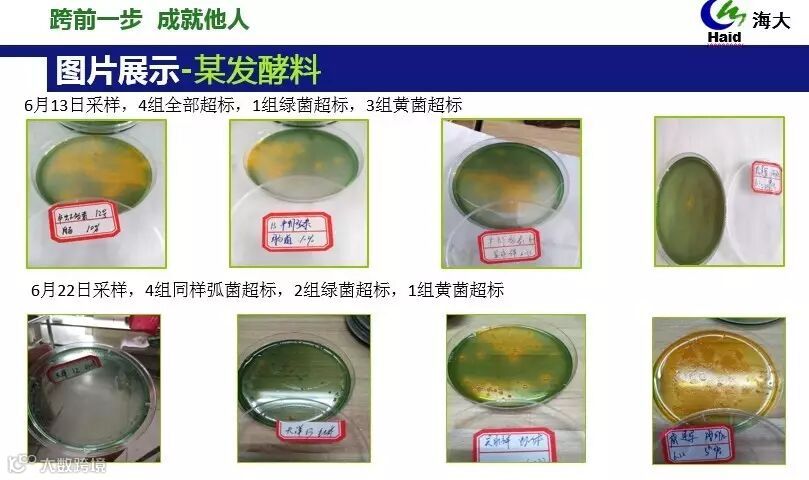

文 | 图 浙江海大 张慧
一、对虾疾病爆发的规律
南美白对虾发病,直接导致减产以及亏损。从多年来疾病爆发的规律来看,我们都会发现以下几种情况伴随出现:底质恶化、倒藻、亚硝酸盐等指标超标、有害菌(弧菌超标)、伴随大蜕壳……如下图:

以上可以归为病因或病源,直接或间接导致南美白对虾养殖中各种疾病的爆发。
体表入侵:一般都是发生在水质指标恶化(亚硝酸高、PH高、)且对虾大批量蜕壳时。
体内爆发:俗话说病从口入,对虾发病,一方面是其免疫力下降,抵御不了病源;另一方面就是藻毒素、含弧菌的残饵粪便等经过摄食进入对虾消化系统,都会引起对虾疾病爆发。
对虾作为甲壳类生物,对病害的免疫和防御是通过内(肝胰脏解毒、内层细胞吞食、淋巴免疫)外(甲壳抵御)结合,共同免疫病,降低病害的发生。
二、白便三板斧,让白便发生率减少一半
浙江区域南美白对虾养殖产量集中上市在6-9月份,外塘养殖对虾占据浙江区域7成以上。这个时间段天气多变,先有梅雨,再有高温台风天气。环境的多变最终引发养殖池塘环境的变化,再加上高投喂,病源积累增加,往往也是对虾爆发疾病的高峰期。
其中近几年开始爆发的白便病害是造成对虾养殖损失最大原因之一。为此,海大技术服务团队结合多年的一线经验围绕浙江区域养殖现状推出“白便防控三板斧”,经推广验证,取得不错的效果。

白便防控三板斧从三个方面预防着手
1、第一板斧:养水全家桶,稳藻相!
2、第二板斧:虾多宝外泼内服,斩弧菌!
3、第三板斧:虾多康,壮虾体!
三、普及浙江萧山、绍兴,数据看效果
本次方案7月份验证,8月份市场推广,普及浙江萧山、绍兴两个对虾集中养殖区域。最终统计市场养殖情况数据,其中三板斧全部使用合计10人,64个塘口;未使用三板斧任何一项的11人,38个塘口。(如下表)
萧山、绍兴区域8月白便发生情况统计

小结分析:
南美白对虾疾病爆发一般是多方面病因综合导致,近几年浙江区域南美白对虾爆发白便病症多是因为底质恶化(弧菌滋生超标)、倒藻及蓝藻爆发引起藻毒素含量高、投喂管理等原因导致对虾本身免疫力下降,肝胰脏损伤等原因。
白便三板斧中:
第一板斧:目的是培养稳定的水体,控藻稳水,预防藻毒素过量;
第二板斧:目的是通过以菌抑菌的手段降低水体和虾体有害菌含量,通过培养有益菌来健康养殖;
第三板斧:正是通过让对虾摄食健康增强抵抗力的功能性饲料来加强对虾的抗病力。

由上图能直观看出,使用三板斧的64个塘口仅仅15个塘口发生白便,白便发生率23%,远远低于没有使用方案塘口的50%白便发生率。再就是发生白便塘口的平均养殖时间也延迟了12天。白便三板斧方案在预防白便以及延迟白便发生方面的使用效果非常明显。白便防控方案经过7月份市场验证总结,去劣取优,最终在8月份组合推出。
第四部分:市场上对三板斧的效果验证
背景:海大萧山养户钱老板,12亩池塘,3月27号放养淡化苗48万,密度530尾/平方苗池标粗;
全家桶使用:5月初开始使用全家桶对大塘调水,7-15天1次使用频率;
水质效果:全程水质稳定,水体肥活嫩爽,指标正常,藻相平衡(下图)。

使用全家桶期间与对比塘口水质指标平均值

使用全家桶的塘口数据组6个,未使用的3个,经检测对比:
1、使用全家桶方案的池塘钙镁磷及总硬度普遍高于未使用全家桶的池塘;
2、使用全家桶的塘口水质稳定,氨氮,亚硝酸平均低于未使用塘口;
3、其中使用全家桶,并坚持按周期的,水质能测出磷含量,其它均未测出。
➤第一板斧:坚持使用全家桶——水质稳定,不易倒藻,蓝藻爆发率也低于市场水平,从而对藻毒素的危害有降低作用,进一步降低白便发生率。
实验方法及步骤:

图片对比展示:

对比效果:

三组明显的对比,横向对比,投喂虾多宝组弧菌超标塘口比例最低;
纵向对比,投喂虾多宝组在6月13日到6月22日期间弧菌有所下降,干拌型虾多宝有明显的抑菌效果。
空白组和投喂某发酵料组弧菌超标塘口在此期间有增加,特别是空白组有2口塘已经空肠空胃,发病处理。
➤第二板斧:补菌补碳源,建立有益菌生存环境,抑制有害菌(弧菌)滋生,维持水体菌藻稳定,水更稳!一二板斧双斧齐下,取得“1+1>2”的好效果。
检测指标:


效果小结:5个塘口前后对比结果如下:
1、离水抗应激实验对比,使用防控白便Q1饲料10天后,离水20分钟放入原塘水平均存活率有原先的42%提高到72%(5个塘口平均),说明对虾的健康程度提升,饲料效果好;
2、肠道色素观察来看,10天后对虾抽样镜检肠道,整体肠道健康度有提升,特别是之前已经出现问题的池塘也有好转;
3、血淋巴凝结时间,使用饲料后平均值由原先的18.1秒到10天后平均14.8秒,免疫力在10天后有提升,虾多康功能料效果显著。
➤第三板斧:通过功能性饲料投喂将对虾自身免疫的提高,配合病源防控。对虾养殖,病害防控就需要这么做!
注:白便的产生原因及详细方案参考《警惕!白便大面积集中爆发,就在8月份!防控你要这三板斧》(点击蓝色字体,即可查看)
浙江海大 精彩文章
养殖模式丨就这个“简易”小棚模式,养虾盈利率达90%,亩利润最高超2万!(附超详细介绍)
罗氏沼虾丨养殖攻略 | 这条虾如何做到成功率90%以上,亩利润5000+
白便防治丨警惕!白便大面积集中爆发,就在8月份!防控你要这三板斧



